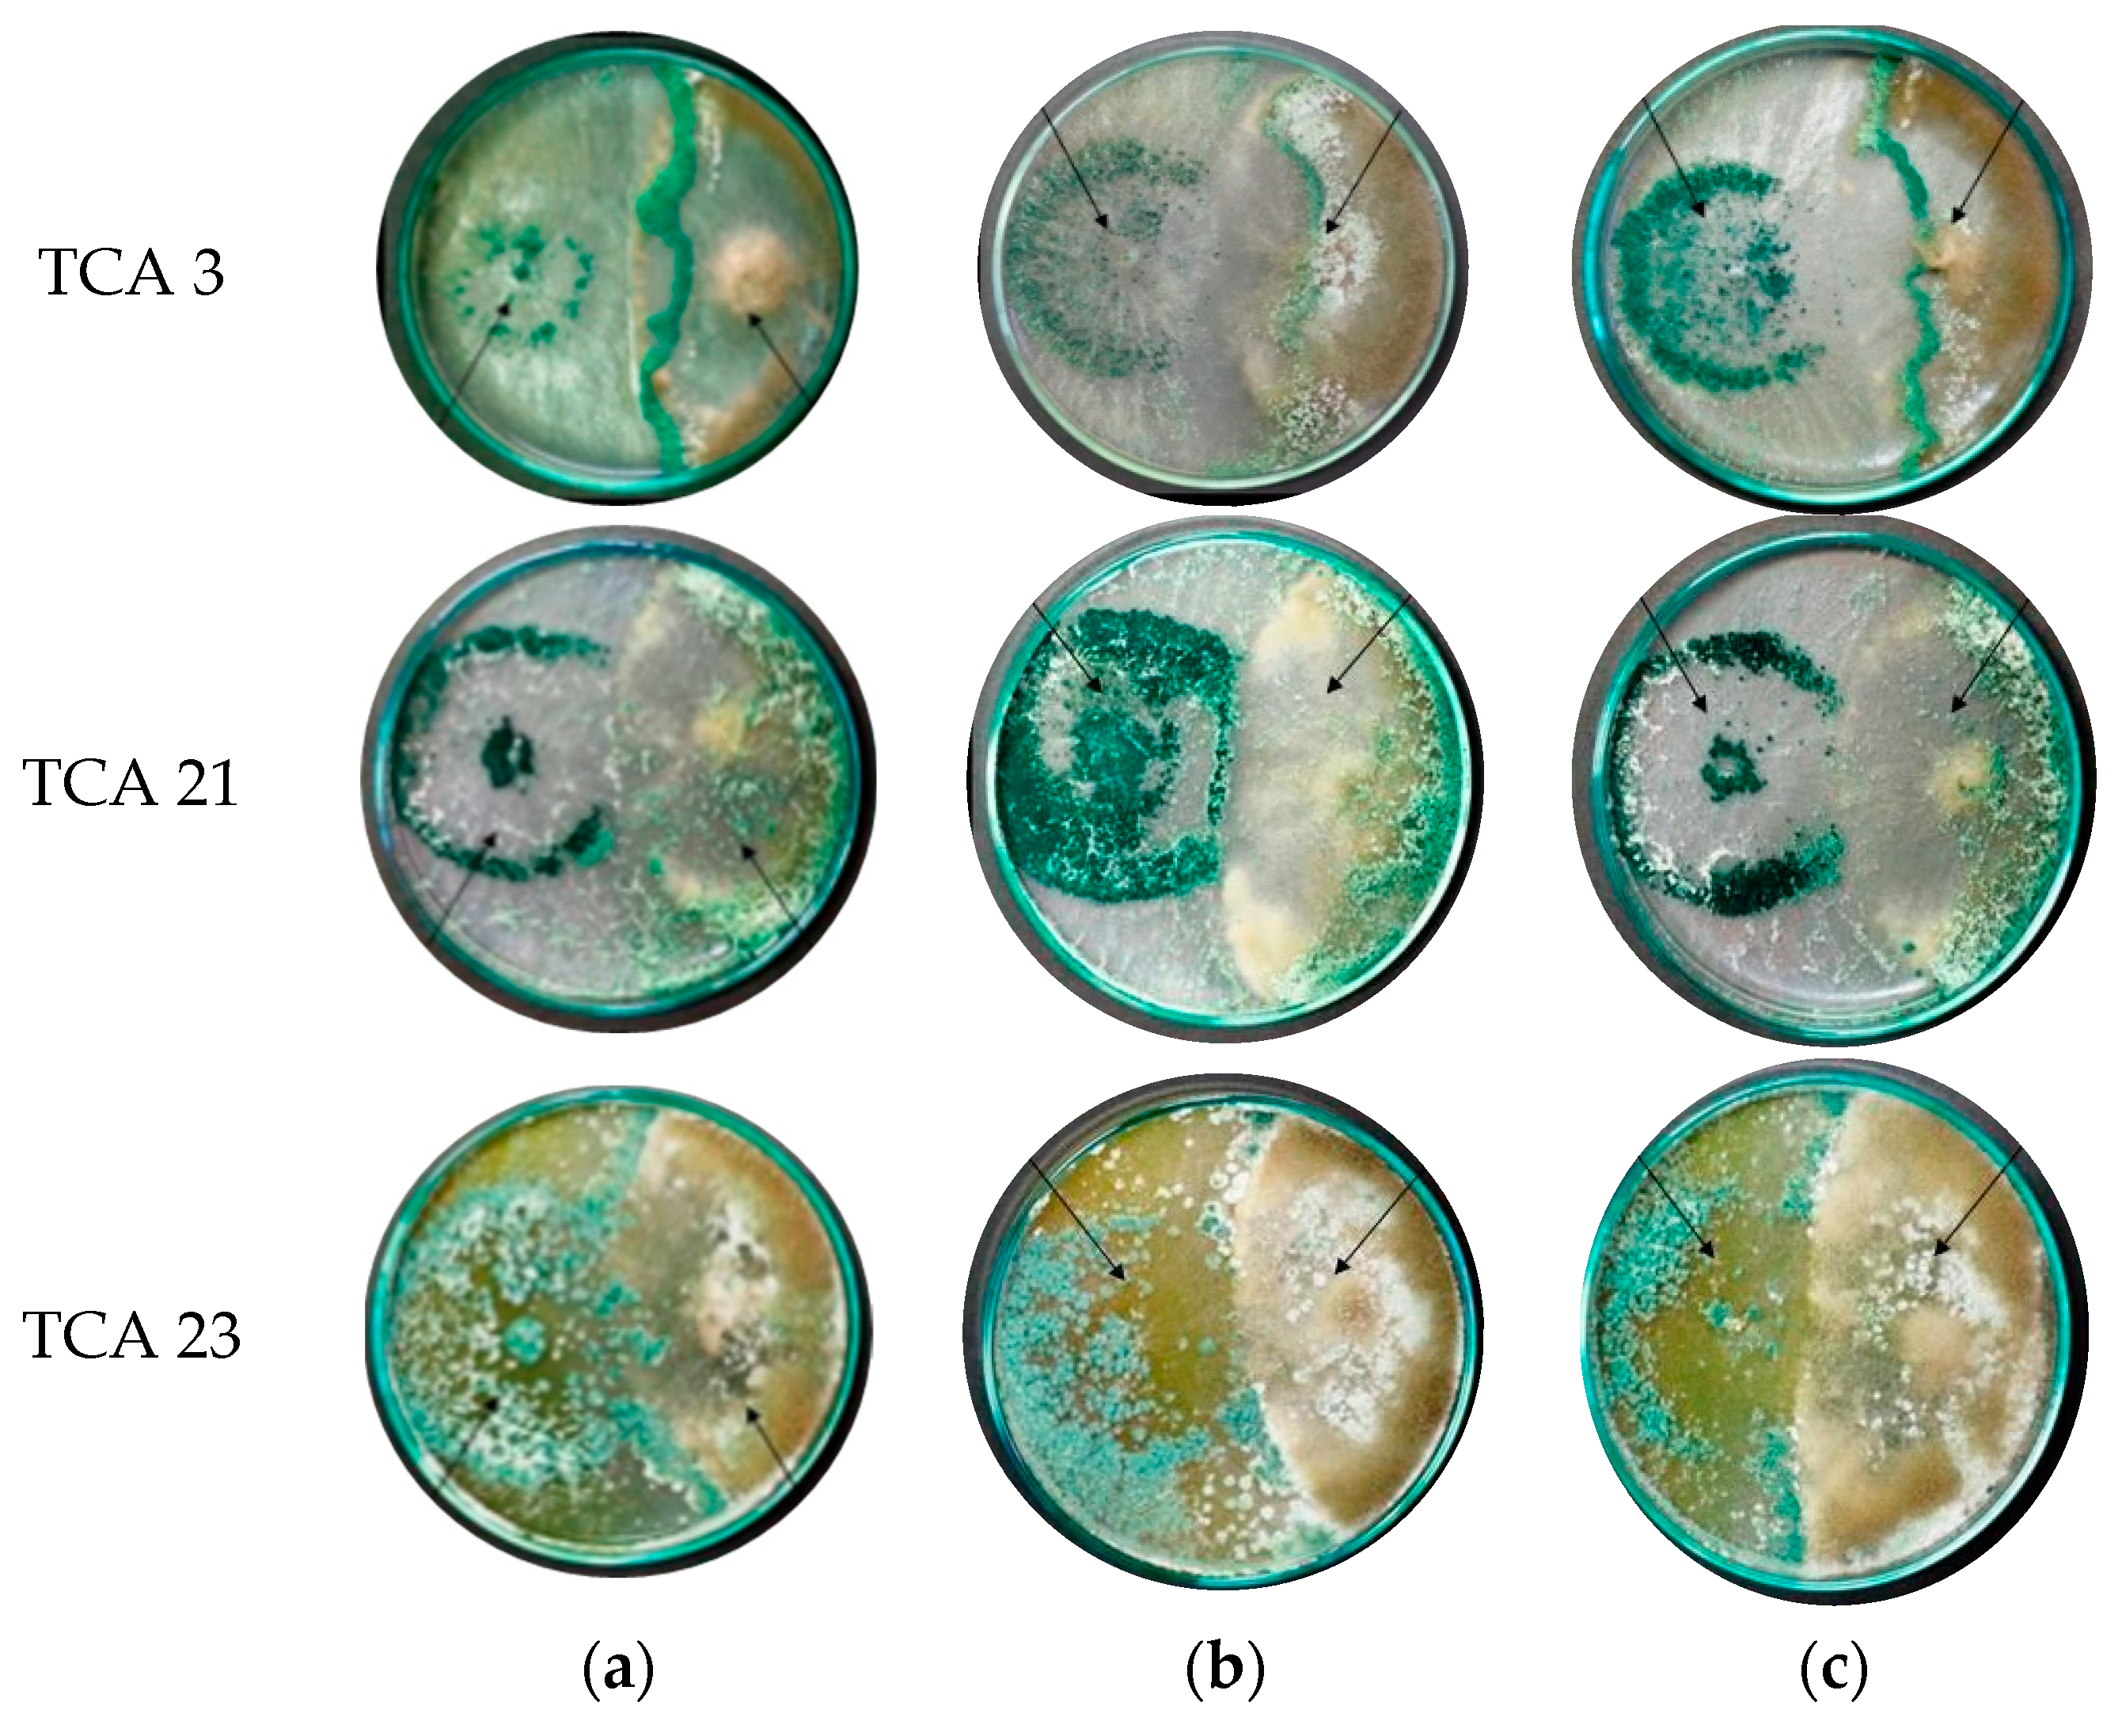
Applsci 13 00811 g003

In Vitro Compatibility of Three Native Isolates of Trichoderma with the Insecticide Chlorpyrifos
Abstract
1. Introduction
2. Materials and Methods
2.1. Culture of Native Trichoderma Isolates
2.2. Insecticide
2.3. Effect of the Insecticide Chlorpyrifos on the Germination of Trichoderma
- G1: average germination of the strain of Trichoderma.
- G2: average germination of the control.
2.4. Effect of the Insecticide Chlorpyrifos on the Growth of Trichoderma
2.5. Effect of the Insecticide Chlorpyrifos on the Antagonistic Capacity of Trichoderma
2.6. Analysis of Data
3. Results
3.1. In Vitro Effect of Chlorpyrifos on the Spore Germination of Native Strains of Trichoderma
3.2. In Vitro Effect of Chlorpyrifos on the Mycelial Growth of Native Strains of Trichoderma
3.3. In Vitro Effect of Chlorpyrifos on the Antagonistic Capacity of the Three Native Strains of Trichoderma
4. Discussion
5. Conclusions
Author Contributions
Funding
Institutional Review Board Statement
Informed Consent Statement
Data Availability Statement
Conflicts of Interest
References
- Behera, B.S.; Rakesh, K.S.S.; Kalifungwa, P.; Sahoo, P.R.; Samal, M.; Sahu, R.K. Plant Disease Detection Using Image Processing Methods in Agriculture Sector. In Intelligent Communication Technologies and Virtual Mobile Networks; Springer Nature Singapore: Singapore, 2023; pp. 759–767. ISBN 9789811918438. [Google Scholar]
- Ortiz, A.; Sansinenea, E. The Role of Beneficial Microorganisms in Soil Quality and Plant Health. Sustainability 2022, 14, 5358. [Google Scholar] [CrossRef]
- Agrios, G.N. Plant Pathogens and Disease: General Introduction. In Encyclopedia of Microbiology; Elsevier: Amsterdam, The Netherlands, 2009; pp. 613–646. ISBN 9780123739445. [Google Scholar]
- Al-Ani, L.K.T.; Furtado, E.L. The Effect of Incompatible Plant Pathogens on the Host Plant. In Molecular Aspects of Plant Beneficial Microbes in Agriculture; Elsevier: Amsterdam, The Netherlands, 2020; pp. 47–57. ISBN 9780128184691. [Google Scholar]
- Sousa, S.; Maia, M.L.; Correira-Sá, L.; Fernandes, V.C.; Delerue-Matos, C.; Calhau, C.; Domingues, V.F. Chemistry and Toxicology behind Insecticides and Herbicides. In Controlled Release of Pesticides for Sustainable Agriculture; Springer International Publishing: Cham, Switzerland, 2020; pp. 59–109. ISBN 9783030233952. [Google Scholar]
- Mandal, A.; Sarkar, B.; Mandal, S.; Vithanage, M.; Patra, A.K.; Manna, M.C. Impact of Agrochemicals on Soil Health. In Agrochemicals Detection, Treatment and Remediation; Elsevier: Amsterdam, The Netherlands, 2020; pp. 161–187. ISBN 9780081030172. [Google Scholar]
- Kaloyanova, F.P.; El Batawi, M.A. Human Toxicology of Pesticides; CRC Press: Boca Raton, FL, USA, 2019; ISBN 9780429266775. [Google Scholar]
- Srivastava, A.K.; Kesavachandran, C. Health Effects of Pesticides; CRC Press: London, UK, 2019; ISBN 9780367175184. [Google Scholar]
- Mali, H.; Shah, C.; Raghunandan, B.H.; Prajapati, A.S.; Patel, D.H.; Trivedi, U.; Subramanian, R.B. Organophosphate Pesticides an Emerging Environmental Contaminant: Pollution, Toxicity, Bioremediation Progress, and Remaining Challenges. J. Environ. Sci. (China) 2023, 127, 234–250. [Google Scholar] [CrossRef]
- Chen, S.; Liu, C.; Peng, C.; Liu, H.; Hu, M.; Zhong, G. Biodegradation of Chlorpyrifos and Its Hydrolysis Product 3,5,6-Trichloro-2-Pyridinol by a New Fungal Strain Cladosporium Cladosporioides Hu-01. PLoS ONE 2012, 7, e47205. [Google Scholar] [CrossRef] [PubMed]
- Maya, K.; Upadhyay, S.N.; Singh, R.S.; Dubey, S.K. Degradation Kinetics of Chlorpyrifos and 3,5,6-Trichloro-2-Pyridinol (TCP) by Fungal Communities. Bioresour. Technol. 2012, 126, 216–223. [Google Scholar] [CrossRef] [PubMed]
- Ck, H. Effect of Pesticide (Chlorpyrifos) on Soil Microbial Flora and Pesticide Degradation by Strains Isolated from Contaminated Soil Hindu. J. Bioremediat. Biodegrad. 2012, 4, 178–182. [Google Scholar] [CrossRef]
- Eaton, D.L.; Daroff, R.B.; Autrup, H.; Bridges, J.; Buffler, P.; Costa, L.G.; Coyle, J.; McKhann, G.; Mobley, W.C.; Nadel, L.; et al. Review of the Toxicology of Chlorpyrifos with an Emphasis on Human Exposure and Neurodevelopment. Crit. Rev. Toxicol. 2008, 38, 1–125. [Google Scholar] [CrossRef]
- Trasande, L. When Enough Data Are Not Enough to Enact Policy: The Failure to Ban Chlorpyrifos. PLoS Biol. 2017, 15, e2003671. [Google Scholar] [CrossRef] [PubMed]
- US EPA. EPA Administrator Pruitt Denies Petition to Ban Widely Used Pesticide; US EPA: Washington, DC, USA, 2017.
- Galagarza, O.A.; Ramirez-Hernandez, A.; Oliver, H.F.; Álvarez Rodríguez, M.V.; Valdez Ortiz, M.D.C.; Pachari Vera, E.; Cereceda, Y.; Diaz-Valencia, Y.K.; Deering, A.J. Occurrence of Chemical Contaminants in Peruvian Produce: A Food-Safety Perspective. Foods 2021, 10, 1461. [Google Scholar] [CrossRef] [PubMed]
- Correa-Núñez, G.; Rojas-Jaimes, J. Uso de plaguicidas no autorizados en alimentos agrícolas primarios, Perú (2011–2018). Mangl. (Tumbes) 2022, 19, 61–65. [Google Scholar]
- Bajda, S.; Grigoraki, L. Integrated Pest Management: Novel Tools, Remaining Challenges, and Intriguing Non-Target Effects. Curr. Opin. Insect Sci. 2020, 39, iii–v. [Google Scholar] [CrossRef] [PubMed]
- Roderick, G.K.; Hufbauer, R.; Navajas, M. Evolution and Biological Control. Evol. Appl. 2012, 5, 419–423. [Google Scholar] [CrossRef] [PubMed]
- He, D.-C.; He, M.-H.; Amalin, D.M.; Liu, W.; Alvindia, D.G.; Zhan, J. Biological Control of Plant Diseases: An Evolutionary and Eco-Economic Consideration. Pathogens 2021, 10, 1311. [Google Scholar] [CrossRef] [PubMed]
- Pirttilä, A.M.; Mohammad Parast Tabas, H.; Baruah, N.; Koskimäki, J.J. Biofertilizers and Biocontrol Agents for Agriculture: How to Identify and Develop New Potent Microbial Strains and Traits. Microorganisms 2021, 9, 817. [Google Scholar] [CrossRef] [PubMed]
- Lahlali, R.; Ezrari, S.; Radouane, N.; Kenfaoui, J.; Esmaeel, Q.; El Hamss, H.; Belabess, Z.; Barka, E.A. Biological Control of Plant Pathogens: A Global Perspective. Microorganisms 2022, 10, 596. [Google Scholar] [CrossRef] [PubMed]
- Pandit, M.A.; Kumar, J.; Gulati, S.; Bhandari, N.; Mehta, P.; Katyal, R.; Rawat, C.D.; Mishra, V.; Kaur, J. Major Biological Control Strategies for Plant Pathogens. Pathogens 2022, 11, 273. [Google Scholar] [CrossRef]
- Nazir, N.; Badri, Z.A.; Bhat, N.A.; Bhat, F.A.; Sultan, P.; Bhat, T.A.; Rather, M.A.; Sakina, A. Effect of the Combination of Biological, Chemical Control and Agronomic Technique in Integrated Management Pea Root Rot and Its Productivity. Sci. Rep. 2022, 12, 11348. [Google Scholar] [CrossRef]
- Sebumpan, R.; Guiritan, K.R.; Suan, M.; Abapo, C.J.; Bhat, A.H.; Machado, R.A.R.; Nimkingrat, P.; Sumaya, N.H. Morphological and Molecular Identification of Trichoderma Asperellum Isolated from a Dragon Fruit Farm in the Southern Philippines and Its Pathogenicity against the Larvae of the Super Worm, Zophobas Morio (Fabricius, 1776) (Coleoptera: Tenebrionidae). Egypt. J. Biol. Pest Control 2022, 32, 1–7. [Google Scholar] [CrossRef]
- Puyam, A. Advent of Trichoderma as a Bio-Control Agent- A Review. J. Appl. Nat. Sci. 2016, 8, 1100–1109. [Google Scholar] [CrossRef]
- Kumar, M.; Ashraf, S. Role of Trichoderma Spp. As a Biocontrol Agent of Fungal Plant Pathogens. In Probiotics and Plant Health; Springer: Singapore, 2017; pp. 497–506. ISBN 9789811034725. [Google Scholar]
- Rush, T.A.; Shrestha, H.K.; Gopalakrishnan Meena, M.; Spangler, M.K.; Ellis, J.C.; Labbé, J.L.; Abraham, P.E. Bioprospecting Trichoderma: A Systematic Roadmap to Screen Genomes and Natural Products for Biocontrol Applications. Front. Fungal Biol. 2021, 2, 716511. [Google Scholar] [CrossRef]
- Sood, M.; Kapoor, D.; Kumar, V.; Sheteiwy, M.S.; Ramakrishnan, M.; Landi, M.; Araniti, F.; Sharma, A. Trichoderma: The “Secrets” of a Multitalented Biocontrol Agent. Plants 2020, 9, 762. [Google Scholar] [CrossRef] [PubMed]
- Zin, N.A.; Badaluddin, N.A. Biological Functions of Trichoderma Spp. for Agriculture Applications. Ann. Agric. Sci. 2020, 65, 168–178. [Google Scholar] [CrossRef]
- Villacorta, W.A.R.; Trigoso, G.J.C.; Wilson, N.E.B.; León, G.M.; Krugg, J.H.W. Aislamiento, selección e identificación de especies nativas de Trichoderma spp. con efecto biocontrolador sobre nematodos noduladores que afectan al cultivo de Asparagus officinalis de la empresa Agroindustrial Camposol S.A. Veritas 2017, 15, 80–91. [Google Scholar] [CrossRef]
- Mukhopadhyay, R.; Kumar, D. Trichoderma: A Beneficial Antifungal Agent and Insights into Its Mechanism of Biocontrol Potential. Egypt. J. Biol. Pest Control 2020, 30, 133. [Google Scholar] [CrossRef]
- Widmer, T.L. Compatibility of Trichoderma Asperellum Isolates to Selected Soil Fungicides. Crop Prot. 2019, 120, 91–96. [Google Scholar] [CrossRef]
- Kumar, J.; Ramlal, A.; Mallick, D.; Mishra, V. An Overview of Some Biopesticides and Their Importance in Plant Protection for Commercial Acceptance. Plants 2021, 10, 1185. [Google Scholar] [CrossRef] [PubMed]
- Silva, R.N.; Steindorff, A.S.; Monteiro, V.N. Metabolic Diversity of Trichoderma. In Biotechnology and Biology of Trichoderma; Elsevier: Amsterdam, The Netherlands, 2014; pp. 363–376. ISBN 9780444595768. [Google Scholar]
- Sain, S.K.; Monga, D.; Kumar, R.; Nagrale, D.T.; Hiremani, N.S.; Kranthi, S. Compatibility of Entomopathogenic Fungi with Insecticides and Their Efficacy for IPM of Bemisia Tabaci in Cotton. J. Pestic. Sci. 2019, 44, 97–105. [Google Scholar] [CrossRef]
- Khun, K.K.; Ash, G.J.; Stevens, M.M.; Huwer, R.K.; Wilson, B.A. Compatibility of Metarhizium Anisopliae and Beauveria Bassiana with Insecticides and Fungicides Used in Macadamia Production in Australia. Pest Manag. Sci. 2021, 77, 709–718. [Google Scholar] [CrossRef]
- Barberis, C.L.; Carranza, C.S.; Magnoli, K.; Benito, N.; Magnoli, C.E. Development and Removal Ability of Non-Toxigenic Aspergillus Section Flavi in Presence of Atrazine, Chlorpyrifos and Endosulfan. Rev. Argent. Microbiol. 2019, 51, 3–11. [Google Scholar] [CrossRef]
- da Silva, M.A.F.; de Moura, K.E.; de Moura, K.E.; Salomão, D.; Patricio, F.R.A. Compatibility of Trichoderma Isolates with Pesticides Used in Lettuce Crop. Summa Phytopathol. 2018, 44, 137–142. [Google Scholar] [CrossRef]
- Ramanagouda, G.; Naik, M.K. Compatibility Studies of Indigenous Trichoderma Isolates with Pesticides. Indian Phytopathol. 2021, 74, 241–248. [Google Scholar] [CrossRef]
- Ríos, M.Á.M.; Villacorta, W.A.R.; Ramos, I.L.M. Crecimiento de Trichoderma asperellum en medio sólido utilizando como única fuente de carbono a los plaguicidas clorpirifos y cipermetrina. UCV Sci. 2019, 11, 149–156. [Google Scholar] [CrossRef]
- Dorsan 48, EC. Available online: https://silvestre.com.pe/productos/dorsan-48-ec/ (accessed on 11 August 2022).
- Dean, R.; Van Kan, J.A.L.; Pretorius, Z.A.; Hammond-Kosack, K.E.; Di Pietro, A.; Spanu, P.D.; Rudd, J.J.; Dickman, M.; Kahmann, R.; Ellis, J.; et al. The Top 10 Fungal Pathogens in Molecular Plant Pathology: Top 10 Fungal Pathogens. Mol. Plant Pathol. 2012, 13, 414–430. [Google Scholar] [CrossRef] [PubMed]
- Bell, D.K. In Vitro Antagonism of Trichoderma species against Six Fungal Plant Pathogens. Phytopathology 1982, 72, 379. [Google Scholar] [CrossRef]
- Mohammadi, A. The Influence of Pesticides and Herbicides on the Growth and Spore Germination of Trichoderma Harzianum. Agric. Sci. Dev. 2015, 4, 41–44. [Google Scholar]
- Whelan, H. Tolerance of Trichoderma Isolates to Forestry Agrichemicals. 2021. Available online: https://researcharchive.lincoln.ac.nz/handle/10182/14759 (accessed on 11 August 2022).
- Sephton-Clark, P.C.S.; Voelz, K. Spore Germination of Pathogenic Filamentous Fungi. Adv. Appl. Microbiol. 2018, 102, 117–157. [Google Scholar] [CrossRef] [PubMed]
- Feofilova, E.P.; Ivashechkin, A.A.; Alekhin, A.I.; Sergeeva, Y.E. Fungal Spores: Dormancy, Germination, Chemical Composition, and Role in Biotechnology (Review). Appl. Biochem. Microbiol. 2012, 48, 1–11. [Google Scholar] [CrossRef]
- Mayo-Prieto, S.; Squarzoni, A.; Carro-Huerga, G.; Porteous-Álvarez, A.J.; Gutiérrez, S.; Casquero, P.A. Organic and Conventional Bean Pesticides in Development of Autochthonous Trichoderma Strains. J. Fungi 2022, 8, 603. [Google Scholar] [CrossRef] [PubMed]
- Prathibha, P.S.; Subaharan, K.; Kumar, A.R.V. Toxicity and Dissipation of Soil Insecticides Applied in the Management of Arecanut White Grub, Leucopholis Burmeisteri Brenk. (Coleoptera: Scarabaeidae). Phytoparasitica 2017, 45, 155–163. [Google Scholar] [CrossRef]
- Bose, S.; Kumar, P.S.; Vo, D.-V.N. A Review on the Microbial Degradation of Chlorpyrifos and Its Metabolite TCP. Chemosphere 2021, 283, 131447. [Google Scholar] [CrossRef]
- Harris, S.D. Hyphal Branching in Filamentous Fungi. Dev. Biol. 2019, 451, 35–39. [Google Scholar] [CrossRef]
- Silambarasan, S.; Cornejo, P.; Vangnai, A.S. Biodegradation of 4-Nitroaniline by Novel Isolate Bacillus sp. Strain AVPP64 in the Presence of Pesticides. Environ. Pollut. 2022, 306, 119453. [Google Scholar] [CrossRef] [PubMed]
- Amaresh, Y.S.; Chennappa, G.; Avinash, S.; Naik, M.K.; Sreenivasa, M.Y. Trichoderma—A New Strategy in Combating Agriculture Problems. In New and Future Developments in Microbial Biotechnology and Bioengineering; Singh, J.S., Ed.; Elsevier: Amsterdam, The Netherlands, 2019; pp. 235–244. ISBN 9780128182581. [Google Scholar]
- Wu, Q.; Ni, M.; Wang, G.; Liu, Q.; Yu, M.; Tang, J. Omics for Understanding the Tolerant Mechanism of Trichoderma Asperellum TJ01 to Organophosphorus Pesticide Dichlorvos. BMC Genom. 2018, 19, 596. [Google Scholar] [CrossRef] [PubMed]
- Mali, H.; Shah, C.; Patel, D.H.; Trivedi, U.; Subramanian, R.B. Degradation Insight of Organophosphate Pesticide Chlorpyrifos through Novel Intermediate 2,6-Dihydroxypyridine by Arthrobacter Sp. HM01. Bioresour. Bioprocess. 2022, 9, 31. [Google Scholar] [CrossRef]
- Alizadeh, R.; Rafati, L.; Ebrahimi, A.A.; Ehrampoush, M.H.; Sedighi Khavidak, S. Chlorpyrifos Bioremediation in the Environment: A Review Article. J. Environ. Health Sustain. Dev. 2018, 3, 606–615. [Google Scholar]
- Fauriah, R.; Amin, N.; Daud, I.D.; Harsanti, E.S. The Potential of Endophytic Fungi as Biodegradation of Chlorpyrifos in Shallots. IOP Conf. Ser. Earth Environ. Sci. 2021, 807, 032058. [Google Scholar] [CrossRef]
- Bisht, J.; Harsh, N.S.K.; Palni, L.M.S.; Agnihotri, V.; Kumar, A. Biodegradation of Chlorinated Organic Pesticides Endosulfan and Chlorpyrifos in Soil Extract Broth Using Fungi. Remediat. J. 2019, 29, 63–77. [Google Scholar] [CrossRef]
- Laura, M.; Snchez-Salinas, E.; Dantn Gonzlez, E.; Luisa, M. Pesticide Biodegradation: Mechanisms, Genetics and Strategies to Enhance the Process. In Biodegradation: Life of Science; Chamy, R., Rosenkranz, F., Eds.; InTech: London, UK, 2013; ISBN 9789535111542. [Google Scholar]
- Singh, B.K.; Walker, A. Microbial Degradation of Organophosphorus Compounds. FEMS Microbiol. Rev. 2006, 30, 428–471. [Google Scholar] [CrossRef]
- Horne, I.; Sutherland, T.D.; Harcourt, R.L.; Russell, R.J.; Oakeshott, J.G. Identification of an Opd (Organophosphate Degradation) Gene in an Agrobacterium Isolate. Appl. Environ. Microbiol. 2002, 68, 3371–3376. [Google Scholar] [CrossRef]
- Kredics, L.; Chen, L.; Kedves, O.; Büchner, R.; Hatvani, L.; Allaga, H.; Nagy, V.D.; Khaled, J.M.; Alharbi, N.S.; Vágvölgyi, C. Molecular Tools for Monitoring Trichoderma in Agricultural Environments. Front. Microbiol. 2018, 9, 1599. [Google Scholar] [CrossRef]
- Mohamed, N.A.; Radwan, M.A. Impact of Pesticides on Trichoderma Harzianum and on Its Possible Antagonistic Activity against Fusarium Oxysporum under in Vitro Conditions. Asian J. Agric. Biol. 2017, 5, 291–302. [Google Scholar]
- Vos, C.M.F.; De Cremer, K.; Cammue, B.P.A.; De Coninck, B. The Toolbox of Trichoderma Spp. in the Biocontrol of Botrytis Cinerea Disease: Trichoderma biocontrol Of Botrytis Cinereadisease. Mol. Plant Pathol. 2015, 16, 400–412. [Google Scholar] [CrossRef] [PubMed]
- Gomes, E.V.; Ulhoa, C.J.; Cardoza, R.E.; Silva, R.N.; Gutiérrez, S. Involvement of Trichoderma Harzianum Epl-1 Protein in the Regulation of Botrytis Virulence- and Tomato Defense-Related Genes. Front. Plant Sci. 2017, 8, 880. [Google Scholar] [CrossRef] [PubMed]
- You, J.; Li, G.; Li, C.; Zhu, L.; Yang, H.; Song, R.; Gu, W. Biological Control and Plant Growth Promotion by Volatile Organic Compounds of Trichoderma Koningiopsis T-51. J. Fungi 2022, 8, 131. [Google Scholar] [CrossRef] [PubMed]
- Bello, F.; Montironi, I.D.; Medina, M.B.; Munitz, M.S.; Ferreira, F.V.; Williman, C.; Vázquez, D.; Cariddi, L.N.; Musumeci, M.A. Mycofumigation of Postharvest Blueberries with Volatile Compounds from Trichoderma Atroviride IC-11 Is a Promising Tool to Control Rots Caused by Botrytis Cinerea. Food Microbiol. 2022, 106, 104040. [Google Scholar] [CrossRef] [PubMed]
- Contreras-Cornejo, H.A.; Orozco-Granados, O.; Ramírez-Ordorica, A.; García-Juárez, P.; López-Bucio, J.; Macías-Rodríguez, L. Light and Mycelial Injury Influences the Volatile and Non-Volatile Metabolites and the Biocontrol Properties of Trichoderma Atroviride. Rhizosphere 2022, 22, 100511. [Google Scholar] [CrossRef]
- Alfiky, A.; Weisskopf, L. Deciphering Trichoderma-Plant-Pathogen Interactions for Better Development of Biocontrol Applications. J. Fungi 2021, 7, 61. [Google Scholar] [CrossRef]
- Wu, X.; Lyu, Y.; Ren, H.; Zhou, F.; Zhang, X.; Zhao, X.; Zhang, G.; Yang, H. Degradation of Oxalic Acid by Trichoderma Afroharzianum and Its Correlation with Cell Wall Degrading Enzymes in Antagonizing Botrytis Cinerea. J. Appl. Microbiol. 2022, 133, 2680–2693. [Google Scholar] [CrossRef]
- Siddhartha, N.S.; Amara, K.V.; Ramya Mol, K.A.; Saju, K.A.; Harsha, K.N.; Sharanappa, P.; Pradip Kumar, K. Evaluation of Substrates for Mass Production of Trichoderma Harzianum and Its Compatibility with Chlorpyrifos + Cypermethrin. Int. J. Curr. Microbiol. Appl. Sci. 2017, 6, 3628–3635. [Google Scholar] [CrossRef]
- Budha, C.B.; Shrestha, S.M.; Manandhar, H.K.; Baidya, S. In-Vitro Compatibility of Some Native Isolates of Trichoderma Spp. with Commonly Used Pesticides. J. Plant Prot. Soc. 2022, 7, 114–122. [Google Scholar] [CrossRef]

| Degree of Antagonism | Criterion |
|---|---|
| 1 | Trichoderma completely outgrows the pathogen colony and covers the surface of the culture medium. |
| 2 | Trichoderma grows on at least two-thirds of the surface of the culture medium. |
| 3 | Trichoderma and the pathogen grow on approximately half the surface of the culture medium (neither seems to dominate the other). |
| 4 | The pathogen grows in at least two-thirds of the culture medium, limiting the growth of Trichoderma. |
| 5 | The pathogen grows on the Trichoderma colony, occupying the culture medium’s entire surface. |
Disclaimer/Publisher’s Note: The statements, opinions and data contained in all publications are solely those of the individual author(s) and contributor(s) and not of MDPI and/or the editor(s). MDPI and/or the editor(s) disclaim responsibility for any injury to people or property resulting from any ideas, methods, instructions or products referred to in the content. |
© 2023 by the authors. Licensee MDPI, Basel, Switzerland. This article is an open access article distributed under the terms and conditions of the Creative Commons Attribution (CC BY) license (https://creativecommons.org/licenses/by/4.0/).
Share and Cite
Sabogal-Vargas, A.M.; Wilson-Krugg, J.; Rojas-Villacorta, W.; De La Cruz-Noriega, M.; Otiniano, N.M.; Rojas-Flores, S.; Mendoza-Villanueva, K. In Vitro Compatibility of Three Native Isolates of Trichoderma with the Insecticide Chlorpyrifos. Appl. Sci. 2023, 13, 811. https://doi.org/10.3390/app13020811
Sabogal-Vargas AM, Wilson-Krugg J, Rojas-Villacorta W, De La Cruz-Noriega M, Otiniano NM, Rojas-Flores S, Mendoza-Villanueva K. In Vitro Compatibility of Three Native Isolates of Trichoderma with the Insecticide Chlorpyrifos. Applied Sciences. 2023; 13(2):811. https://doi.org/10.3390/app13020811
Chicago/Turabian StyleSabogal-Vargas, Ana María, Juan Wilson-Krugg, Walter Rojas-Villacorta, Magaly De La Cruz-Noriega, Nelida Milly Otiniano, Segundo Rojas-Flores, and Karol Mendoza-Villanueva. 2023. "In Vitro Compatibility of Three Native Isolates of Trichoderma with the Insecticide Chlorpyrifos" Applied Sciences 13, no. 2: 811. https://doi.org/10.3390/app13020811
APA StyleSabogal-Vargas, A. M., Wilson-Krugg, J., Rojas-Villacorta, W., De La Cruz-Noriega, M., Otiniano, N. M., Rojas-Flores, S., & Mendoza-Villanueva, K. (2023). In Vitro Compatibility of Three Native Isolates of Trichoderma with the Insecticide Chlorpyrifos. Applied Sciences, 13(2), 811. https://doi.org/10.3390/app13020811

